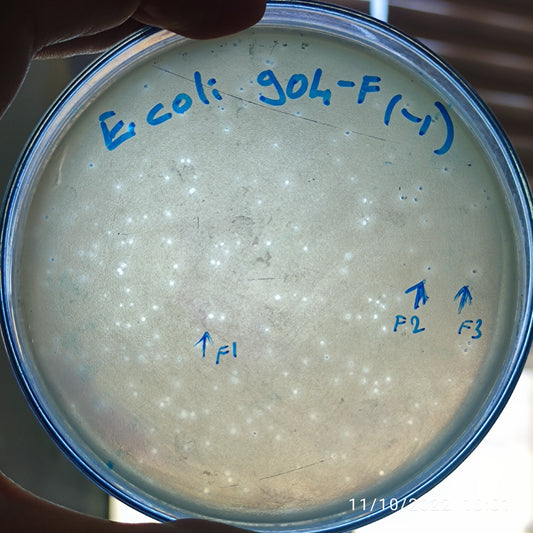
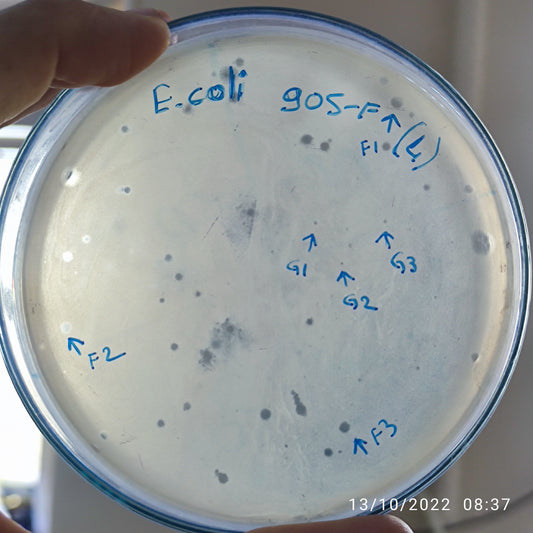
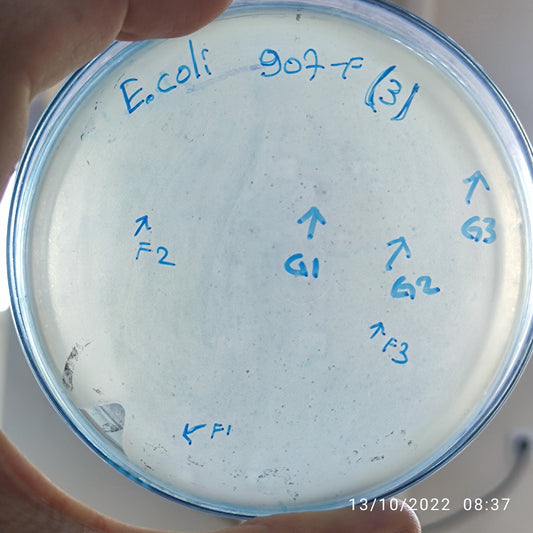
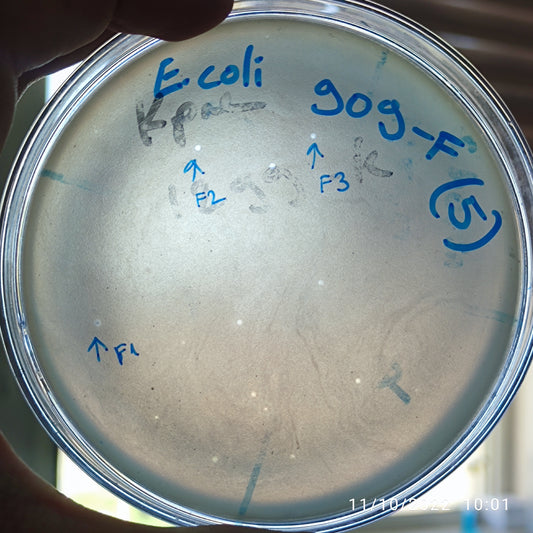
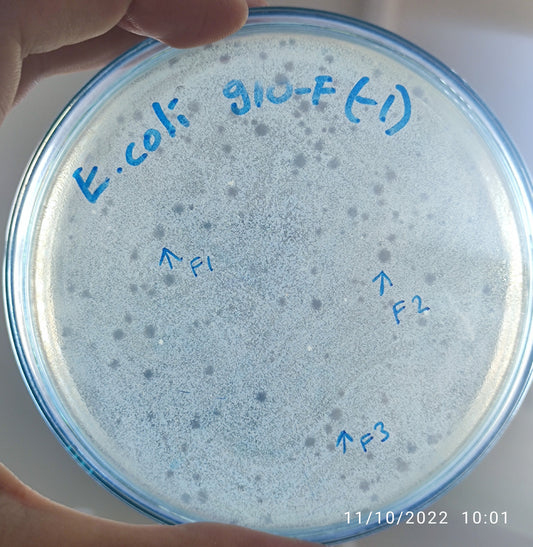
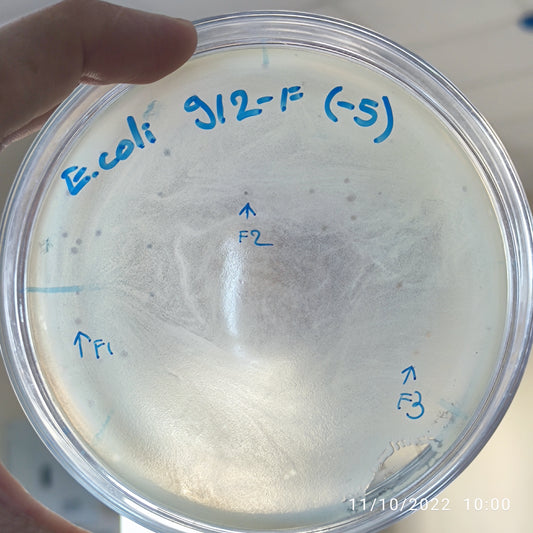
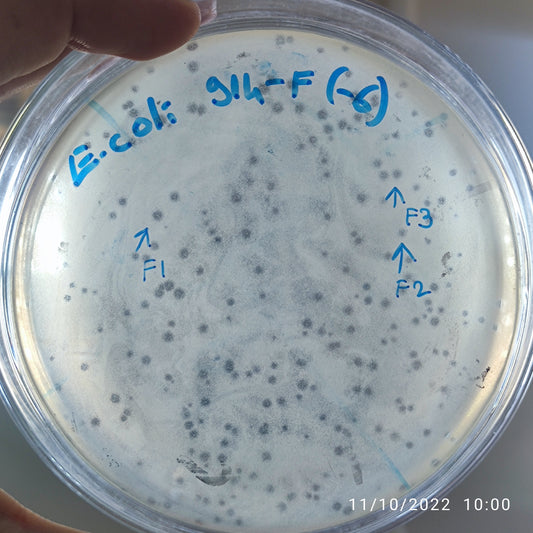
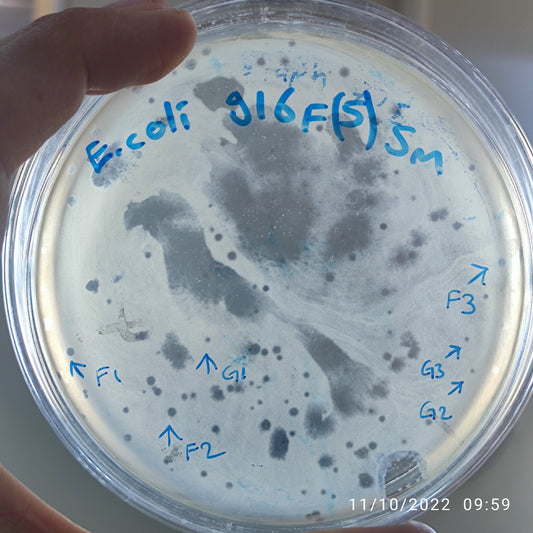
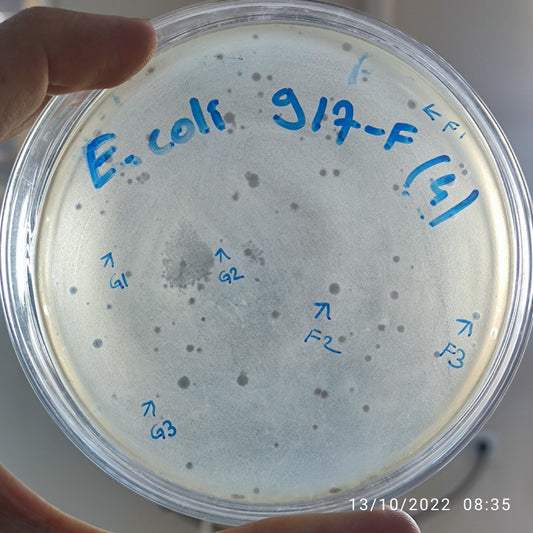
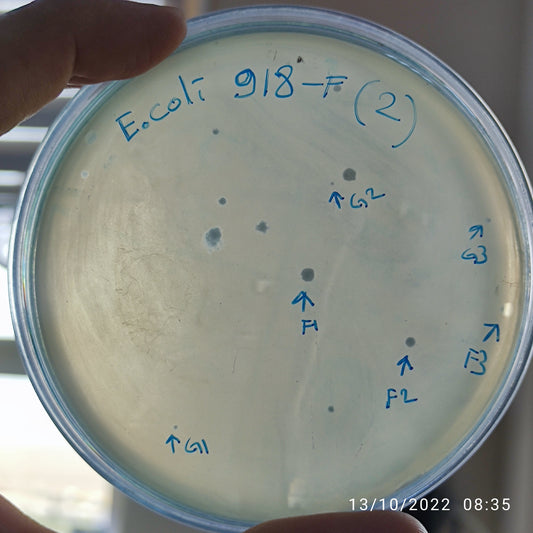

-
Escherichia coli bacteriophage 100902G
Regular price $0.00 USDRegular priceUnit price per -
Escherichia coli bacteriophage 100904F
Regular price $650.00 USDRegular priceUnit price per -
Escherichia coli bacteriophage 100905F
Regular price $500.00 USDRegular priceUnit price per -
Escherichia coli bacteriophage 100905G
Regular price $500.00 USDRegular priceUnit price per -
Escherichia coli bacteriophage 100907F
Regular price $500.00 USDRegular priceUnit price per -
Escherichia coli bacteriophage 100907G
Regular price $500.00 USDRegular priceUnit price per -
Escherichia coli bacteriophage 100909F
Regular price $700.00 USDRegular priceUnit price per -
Escherichia coli bacteriophage 100910F
Regular price $500.00 USDRegular priceUnit price per -
Escherichia coli bacteriophage 100912F
Regular price $600.00 USDRegular priceUnit price per -
Escherichia coli bacteriophage 100914F
Regular price $700.00 USDRegular priceUnit price per -
Escherichia coli bacteriophage 100915F
Regular price $500.00 USDRegular priceUnit price per -
Escherichia coli bacteriophage 100916F
Regular price $600.00 USDRegular priceUnit price per -
Escherichia coli bacteriophage 100916F
Regular price $500.00 USDRegular priceUnit price per -
Escherichia coli bacteriophage 100917F
Regular price $500.00 USDRegular priceUnit price per -
Escherichia coli bacteriophage 100917G
Regular price $500.00 USDRegular priceUnit price per -
Escherichia coli bacteriophage 100918F
Regular price $500.00 USDRegular priceUnit price per